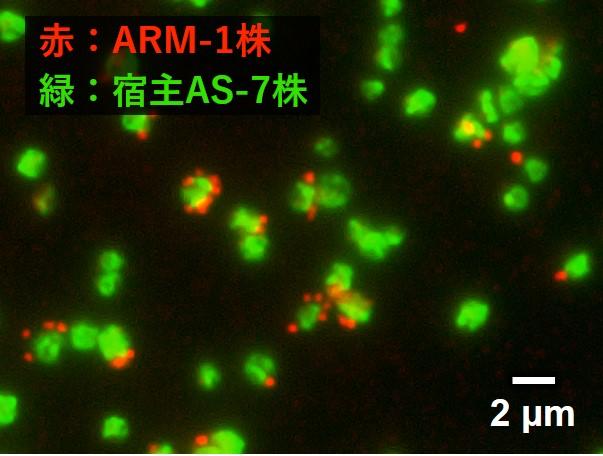
【創価大学】DPANN群に属する難培養性アーキアの培養に成功。寄生性アーキアの新しい生理生態を発見

創価大学のプロフィールページ

- URL https://www.soka.ac.jp/
- 住所 東京都八王子市丹木町1-236
-
概要
建学の精神に基づき、地域社会や地球社会の課題と真摯に向き合い、人々の幸福と世界の平和の実現に貢献する「創造的人間」、すなわち、価値創造を実践する「世界市民」の育成を目指します。
そのために、たしかな「知力」を基盤とし、不確かな未来を切り開く「創造性」を発揮する力、協働する人々の価値観や理念など「多様性」を受容(寛容)する力を育む教育に取り組みます。 - 学長(学校長) 鈴木美華